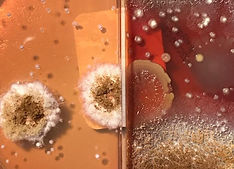
WhatsApp Image 2022-06-04 at 1.40_edited.jpg

Estudios microbiológicos
Te permite identificar la presencia y el tipo de microorganismos que pueden afectar a tu obra, como hongos y bacterias. Con este análisis puedes prevenir o tratar posibles infecciones, manchas o daños.
El Museo de Ciencia y Tecnología tiene el interés de prevenir el riesgo de contraer enfermedades causadas por hongos y bacterias en el manejo de bienes patrimoniales. El enfoque médico que se le asignó fue para la salud de los trabajadores, restauradores, conservadores, curadores, museógrafos que entran en contacto con objetos patrimoniales y obras de arte.
Los primeros estudios micro-biológicos para la detección de hongos que se realizaron en la UPC fueron para: un mural perteneciente al Hospital de la Mujer en Guadalajara, Jalisco; una escultura en madera policromada de un Cristo articulado proveniente de Amatitlán de Caña, Nayarit, entre otras. Se ha trabajado con instituciones como la Escuela de Restauración y Conservación de Occidente (ECRO) y el Instituto Nacional de Antropología e Historia (INAH) de Nayarit.

.png)